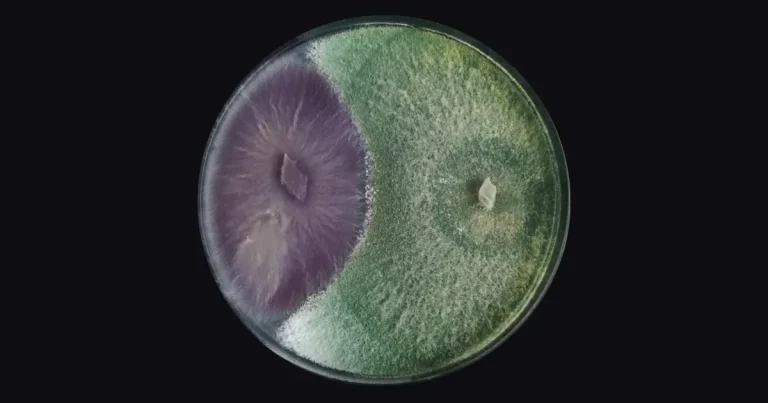

Biotecnología agrícola: El dilema entre tradición e innovación
La biotecnología agrícola se ha convertido en un pilar fundamental para alcanzar cultivos más sostenibles y eficientes. Con un enfoque…
en Agricultura Sostenible y Biotecnología
La biotecnología agrícola se ha convertido en un pilar fundamental para alcanzar cultivos más sostenibles y eficientes. Con un enfoque…

¿Cuál es la mejor elección para tu cultivo? ¿Te has preguntado alguna vez cuál es la diferencia entre la agricultura…

En la producción de maíz, el desarrollo temprano de raíces fuertes y un tallo resistente son fundamentales para maximizar el…

La producción sostenible de agave tequilana es un desafío cada vez mayor. Con la demanda creciente de tequila, los productores…

La violeta de Persia (Viola tricolor), conocida en México también como pensamiento o flor tricolor, es una planta ornamental popular…

Cuando se trata de maximizar el rendimiento en chile serrano, los métodos tradicionales de fertilización y control de enfermedades a…